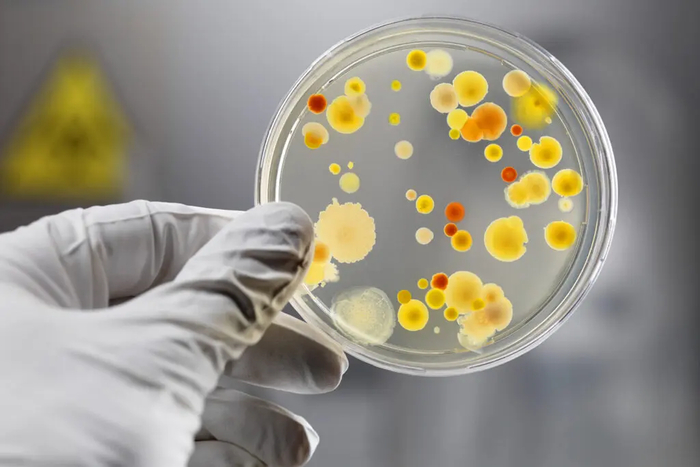
.  iStock

Сегодня модно всюду выискать красные флаги. Нас учат распознавать их в партнерах, родственниках, в кошке и даже в себе. Но что насчет красных флагов в мире медицины? Как отличить нормального врача от эталонного мракобеса? Представляю вашему внимание прикладное руководство на примере одного любопытного персонажа – доктора Берга. Спойлер: он на самом деле не доктор, а хиропрактик. А еще продавец чудо-БАДов и, член одной интересной религиозной организации, верящей в инопланетян. Зато с 7 млн подписчиков на русскоязычном канале и 13 млн – на англоязычном.
Если бы в палате мер и весов хранился эталон медицинского мракобеса, это был бы доктор Берг, а других мракобесов можно было бы оценивать в микробергах. Но главный парадокс и глобальная несправедливость – в том, что любой терапевт в вашей районной поликлинике в миллион раз компетентней Берга. Но советы о том, как правильно жить и лечиться, вероятно, вы слышали именно от последнего.
Первый красный флаг. Доктор не настоящий!
Начнем с очевидного. “Доктор Берг” на самом деле не доктор, по образованию он – хиропрактик. На его сайте есть дисклеймер, хоть и маленькими буквами. Если что, хиропрактика – это направление псевдомедицины, где всё лечат воздействиями на позвоночник. Методику лечения основателю хиропрактики Даниэлю Палмеру “сообщила” духовная сущность погибшего доктора Джима Аткинсона. Во время спиритического сеанса.
Разумеется, к нормальной медицине это направление отношения не имеет. Первый красный флаг.
Но знаете, что самое смешное в этой ситуации? Доктор Берг – мракобес даже по мерками хиропрактиков. Они погнали его куда подальше. Дело в том, что Берг шесть лет работал в «Центре здоровья и благополучия» в Вирджинии, где занимался хиропрактикой, пока не получил дисциплинарное взыскание.
Второй красный флаг. Альтернативная медицина
Берг продвигал методику восстановления тела, при которой флаконы с дистиллированной водой, содержащие гомеопатическую память воды, размещались над определенными частями тела пациента. Пока врач нажимал или постукивал по аккупунктурным точкам. Комбо! Делалось это для восстановления баланса гормонов. Также Берг предлагал пациентам лечить аллергию через надавливание на определенные точки и анализировал потоки энергии в их теле.
Звучит так, будто Берг решил собрать все практики альтернативной медицины, как Танос собирал камни бесконечности, а Эш Кэтчум – Покемонов.
И, разумеется, слова “гомеопатия”, “память воды”, “акупунктурные точки” и всякие там мистические циркулирующие энергии – это тоже красные флаги и дичь дичайшая, особенно из уст якобы врача.
Третий красный флаг. Заговор злой фармы
Когда якобы врач уходит в антинаучную медицину, к нему возникает резонный вопрос. А почему же ваши чудо-методы не признаны нормальными врачами? Где Нобелевская премия за лечение геморроя огурцом, не оторванным от ботвы? Тут на помощь приходят теории заговора.
Это вообще один из самых верных признаков ерунды. Обычные врачи, дескать, скрывают натуральные лекарства. Потому что это не выгодно злой фарме! Вместо этого они травят людей обычными лекарствами с кучей ядов и побочных эффектов. А мы не такие! Вот цитата с сайта доктора Берга, описывающая его путь в медицине: “Уже тогда его начали интересовать безопасные, натуральные способы оздоровления организма — без использования лекарств и других методов, которые могут оказывать вредное побочное действие”.
Тут сразу несколько мифов. Во-первых, натуральные лекарства, если они проходят все стадии проверок, прекрасно вписываются в медицину и выписываются обычными врачами. Тот же аспирин - лекарство, изначально обнаруженное в коре ивы. Стоит он копейки, и никто его не скрывает.
Просто псевдоврачи любят представлять идеи альтернативной медицины как тайное знание, хотя на самом деле это объедки того, что в настоящую медицину брать постеснялись. Либо за отсутствием доказанной эффективности, либо из-за побочек. Ведь натуральное – не значит безопасное. И вообще, эффективных лекарств, лишенных побочных эффектов, не бывает. Важно соотношение вреда и пользы.
Во-вторых, нарратив конспиролога предполагает заговор миллионов специалистов. Представьте: во имя сокрытия чудодейственных свойств сока сельдерея при лечении рака были куплены тысячи ученых, врачей, редакторы научных журналов, директора медицинских учреждений. Все куплены. Кроме Доктора Берга, который, конечно, совершенно бескорыстно продает свою линейку БАДов. Всего за 42 евро вы можете купить его пудру с электролитами и запудрить ей свои мозги, а за 110 евро – “бустер для иммунитета”, работающий на кошельковой тяге.
Хорошо. Но какие же “безопасные, натуральные способы оздоровления организма” предлагает Берг своим зрителям? Например, он призывает лечить герпес и вирус Эпштейна-Барра душицей обыкновенной.
Причём тезис о противовирусной эффективности душицы основывается исключительно на исследованиях in vitro, в пробирке. Сейчас я побуду душницей и скажу, что это самый ранний этап исследований, на котором еще рано делать выводы. И я утверждаю, что как только появятся данные об эффективности душицы на реальных пациентах, а не фантазиях, ее начнут назначать и обычные врачи. Как случилось с ромашкой в качестве противовоспалительного средства.
При этом против герпеса есть реально работающие препараты – например, ацикловир, мешающий вирусу размножаться. Эффективность подтверждена десятком рандомизированных клинических исследований на людях и метаанализами.
Есть такое определение альтернативной медицины, которое я не устаю повторять. Его придумал австралийский музыкант Тим Минчин. Альтернативная медицина – это медицина, про которую либо не доказано, что она работает, либо доказано, что она не работает. Знаете, как называется доказанно работающая альтернативная медицина? Медицина.
Разумеется, желание обличать фарму и продавать БАДы не доводят до хороших рекомендаций. В одном из видео Берг говорит, что есть тайное лекарство от сердечных приступов, о котором вы не слышали. Почему не слышали? Потому, что нет денег в этой области. 3 доллара стоит пузырек! Правда, на сайте доктора Берга чудо-средство стоит уже 20 евро. Но что же это за средство такое? Никотиновая кислота. Ниацин. Одна из форм витамина B3.
В своем видео про ниацин доктор Берг ссылается на статью в европейском журнале клинической фармакологии. Эта статья является дополнением к статье 1975 года в журнале JAMA. Тогда ученые взяли более 8000 пациентов и разбили их на шесть групп, из которых одна получала ниацин, и еще одна – плацебо. Авторы сразу отмечают, что на ниацине была масса побочек. Если в плацебо-группе 4% испытуемых покинули исследование досрочно, в группе ниацина таких было 14%. Побочки от избытка ниацина включают характерную красную сыпь, аритмию и прочее. Зато в группе ниацина было чуть меньше сердечных приступов. Хотя это касалось только несмертельных вариантов этого недуга – и на общую смертность не влияло никак. Причем даже в случае несмертельных сердечных приступов непонятно, не было ли это эффектом плацебо, так как исследование с ниацином из-за побочек сложно сделать слепым. Авторы пришли к выводу, что ниацин не способствует выживанию пациентов. Отличное, конечно, доказательство пользы.
Но Берг ссылается не на само исследование, а на его развитие. Много лет спустя ученые проанализировали пациентов из исходной работы и обнаружили сниженную смертность в группе, которая принимала ниацин, а потом перестала. Как это интерпретировать, не очень понятно – учитывая, что исследование не было полноценно слепым, а в группе ниацина 14% пациентов выбыло еще в самом начале. При этом свежие метаанализы говорят, что, хотя в старых исследованиях полезные эффекты от ниацина для сердечно-сосудистой системы наблюдались, при современных терапиях его польза не обнаружена. Более того, ряд авторов предостеграют, что избыточное потребление ниацина может ухудшить состояние сердечно-сосудистой системы. А ведь его избыточное потребление достигается довольно легко – во многих странах ниацин добавляют в различные продукты питания типа муки или хлопьев для профилактики пеллагры. Принимать ниацин дополнительно без медицинских оснований – решение спорное.
А ещё Берг отговаривает людей принимать препараты с хорошо обоснованной эффективностью. Например, статины. Эффективность статинов для предотвращения целого ряда сердечно-сосудистых заболеваний подтверждается метаанализами. Снижается и смертность, и частота подобных болезней.
Четвертый красный флаг. Противник прививок
Забавно, как Берг говорит о прививках. Будто он тайный шпион в стане врага. Однажды Берг очень пространно высказался, что нашел одно исследование про негативные последствия вакцины от ковида. И там якобы говорится, что эта вакцина ослабляет иммунитет. Только вот нюанс: в данном случае никакого научного исследования и нет. Берг ссылается на письмо, в котором автор делится своим мнением о том, что вакцинация ослабляет иммунитет. А вот уже автор письма ссылается на исследование эффективности вакцинации от ковида в журнале The Lancet, но почему-то Берг пересказывает письмо, а не саму статью.
Возможно, дело в выводах оригинальной работы. В ней говорится, что вакцины от ковида эффективны, просто со временем их полезность снижается. Не иммунитет снижается, а полезность. То есть авторы подчеркивают важность ревакцинации. Получается, Берг взял статью, призывающую вакцинироваться чаще, и сделал из нее «доказательство» вреда вакцин.
Впрочем, справедливости ради, доктор Берг не отрицает все вакцины. Во всяком случае на его сайте я нашел утверждение о том, что вакцины все-таки могут быть эффективны против некоторых вирусов, в частности, против вируса кори. И все же мы получаем довольно полный портрет медицинского конспиролога. Знаете, есть замечательное исследование о том, что люди, верящие в теории заговора, сами чаще готовы в них участвовать. И то, в чем Берг обвиняет врачей, относится скорее к нему самому. Он пудрит людям мозги, чтобы продавать добавки.
Пятый красный флаг. Выборочное цитирование
Есть такой термин – черрипикинг. Это когда человек выбирает только те данные, примеры или факты, которые подтверждают его точку зрения, игнорируя всё, что ей противоречит. Очевидно, что у Берга есть особо теплые чувства к мясу. Настолько теплые, что он называет красное мясо лучшим продуктом для исцеления организма. А о его недостатках говорит весьма неохотно. Хотя, например, Международное агентство по изучению рака, входящее в структуру ВОЗ, давно классифицировало переработанное мясо как канцероген, а красное мясо как вероятный канцероген. Но Берга это не беспокоит. Для него красное мясо – главный источник молодости, силы и чуть ли не вселенского просветления.
Степень отрицания науки Бергом в этом вопросе поражает. Он считает, что мясо специально демонизируют в медиа. Просто игнорируйте эти исследования, говорит он. И перечеркивает их на своей белой доске. Прежде всего, Берг призывает игнорировать наблюдательные исследования. Это когда сравнивают людей с одним образом жизни и с другим, делая поправку на прочие отличия между группами – вроде пола или возраста. Мол, как можно верить исследованию, в котором людей просто опрашивали о том, что они ели? Вдруг рак вызвал не стейк, а съеденная после него булочка? С такими аргументами можно дойти и до отрицания связи между курением и раком легких. Ведь именно наблюдательные исследования в свое время показали, что курение вызывает рак. Тогда, кстати, тоже были люди, которые говорили, что это все неправильно, и, наоборот, рак вызывает курение.
Действительно, установление причинно-следственных связей без полноценного рандомизированного клинического исследования проблематично. И все же правильно составленные наблюдательные исследования учитывают все значимые факторы, которые приходят в голову ученым: возраст, пол, пищевые привычки, спорт, курение, потребление алкоголя. Всё, что теоретически может повлиять на результат. И если мы видим, что даже после поправок на все перечисленное потребление красного мяса повышает риск некоторых видов рака, этому аргументу стоит доверять. Но доктор Берг будто бы упорно делает вид, что не понимает, как такие исследования работают.
Но если уж говорить начистоту, следуя советам Берга, полезно не мясо вообще, а мясо правильное. Если коровка паслась на лугу, жевала травку, смотрела закаты и была счастлива — мясо у нее полезное, ешьте на здоровье. А вот если корова сидела в амбаре и ела модифицированное зерно — фу, токсичное мясо, выплюньте его немедленно. Именно от него все проблемы, о которых говорят мясоненавистники. У них просто мяса нормального не было.
Я не демонизирую мясо. Я сам его ем. Но разница в том, что Берг себя возомнил всезнающим гуру, каждое действие которого пропитано мудростью, не иначе. А признать: «ем мясо, понимаю риски, но отказаться не могу» — это слишком по-человечески. Так что он не свои вкусы подгоняет под науку, а науку под свои вкусы. Снимает видео о «заговоре против мяса», выстраивает целую систему оправданий и объявляет себя единственным носителем правды.
И раз уж мы говорим о еде, знаете что? Доктор Берг ест по 4–5 штук куриных яиц в день и предлагает делать то же самое своей аудитории. Это еще один продукт, потребление которого он продвигает в своих видео. Яйца я тоже не собираюсь демонизировать. Но пять штук в день? Почему? Берг утверждает, что яйца невероятно полезны, потому что «сорок восемь процентов яйца превращается в ткани организма». Почему сорок восемь? Почему не сорок два? Если следовать такой логике, после килограмма яиц я автоматически наберу 480 грамм массы тела?
Доктор Берг уверяет, что нет никаких данных, указывающих на связь между яйцами и повышением уровня «плохого» холестерина — то есть липопротеинов низкой плотности. Но проблема в том, что такие данные есть.
Вообще яйца очень беспокоят доктора Берга. В одном видео он как бы невзначай упоминает, что его на время перестали приглашать на мероприятия ExxonMobil. Он решил узнать, почему, а ему ответили: за совет есть сорок пять яиц в день. Позже он пояснил, что говорил про 4-5 яиц в день, и его снова стали приглашать. Эта история смешная по двум причинам. Во-первых, тем как Берг пытается намекнуть, мол, смотрите какой я крутой, меня приглашают в ExxonMobil. А во-вторых, что кто-то из его аудитории подумал, что про 45 яиц в день может быть сказано всерьез. Классная репутация.
Шестой красный флаг. Замена лекарств диетами
Правильное питание может влиять на жизнь человека, но красный флаг возникает, когда еда представляется панацеей чуть ли не ото всех болезней. Доктор Берг пытается лечить диетами практически всё. Вплоть до СДВГ и аутизма. Причем ладно бы на каждую болезнь была своя диета – как безглютеновая для целиакии. У Берга диета одна на всех – кетодиета.
Кетодиета – это питание с очень низким содержанием углеводов, высоким содержанием жиров и умеренным – белков. Она нужна, чтобы перевести организм в состояние кетоза, когда тело начинает черпать энергию не из углеводов, а из жиров. И Берг советует ее всем подряд, совершенно не учитывая исследования, касающиеся конкретных углеводосодержащих продуктов. Например, есть куча работ о том, что потребление цельнозерновых злаков связано со сниженным риском возникновения диабета второго типа и преждевременной смертности у взрослых с диабетом. Но Доктор Берг говорит: долой углеводы! Зато яйца ешьте сколько хотите.
Но что говорит нам наука? Что много углеводов – плохо, но и мало углеводов – тоже плохо. Самая низкая смертность наблюдается у людей, потребляющих примерно половину калорий в виде углеводов. Об этом было исследование 2018 года на выборке в 15 тыс. человек. А метаанализ нескольких когорт с общим числом участников более 430 тыс. человек показал: значительно повышенная смертность наблюдалась как при потреблении менее 40%, так и более 70% калорий из углеводов. Согласно последним данным, углеводы должны составлять от 45% до 65% суточной калорийности рациона.
Еще доктор Берг рекомендует интервальное голодание, хотя доказанной безопасности и долгосрочной эффективности у него нет. Все это может помочь временно похудеть, но за пределами этого пользы мы не видим.
Если говорить про научную подоплеку этого безобразия, то есть хорошие исследования об увеличении продолжительности жизни за счет уменьшения калорий. Но только не на людях. А вот на людях есть работы, показавшие, что самая низкая смертность наблюдается у тех, кто потребляет усредненное количество углеводов. Для мужчин это где-то 2700 ккал в сутки, для женщин – 2200.
Седьмой красный флаг. “Холистический подход”
Холистический подход — это концепция, согласно которой систему, например, человека или общество, нужно рассматривать как единое целое, а не просто как сумму её частей. В медицине это может значить что-то типа “лечить не болезнь, а пациента с учетом его индивидуальных особенностей и пожеланий”. Звучит хорошо, но вы вряд ли услышите такие слова от нормального врача, так как термин слишком часто используют, чтобы придать наукообразность ненаучным методам лечения.
Если спросить онколога, как работает препарат, он, вероятно, объяснит это в конкретных научных терминах. Он не будет ссылаться на абстрактные, мало чего значащие слова: что лекарство лечит не рак, а организм. Посмотрите, кстати, как термин используется в сериале BBC Дирк Джентли, холистический детектив. Вот это близко к реальному словоупотреблению.
А что же с “холистической медициной”? Всё взаимосвязано друг с другом. Наш организм един. Мы едины с природой. Всё должно быть натуральным. В своей радикальной форме весь этот высокодуховный взгляд на мир может вообще приводить к отрицанию болезней как таковых. Причем сторонники этого подхода, якобы стараясь рассматривать организм как единое целое, не очень-то стремятся разобраться в молекулярной генетике или биохимии.
Еще сторонникам такого подхода часто свойственно ложное убеждение о том, что всё возникающее в нашем организме – это полезная реакция. А большинство внешних вмешательств в работу тела приведут к чему-то плохому. В одном из разборов доктора Берга настоящий врач отмечает, что Берг называет гормон инсулин очень токсичным. Он доходит до того, что называет диабет второго типа защитным механизмом на избыточность инсулина. Типа это такая полезная природная адаптация. А плохие врачи колят диабетикам больше токсичного инсулина, чем делают все только хуже.
И тут мы вспоминаем, что Доктор Берг не совсем “доктор”. Потому что это поразительное непонимание диабета. Постоянных инъекций инсулина требует диабет первого типа. Он связан с гибелью клеток, которые должны производить этот гормон. Инсулина не хватает, приходится добывать его извне, никакого избытка нет. А вот диабет второго типа связан с тем, что инсулин производится, но к нему снижена чувствительность. Только вот при нем инсулин будут колоть в самых крайних случаях, а для лечения как раз раз советуют изменить образ жизни и гасить болезнь препаратами условного метформина, снижающего уровень сахара в крови. То есть лекарственная терапия будет направлена не на выработку инсулина, а на регулирование уровня глюкозы. И, конечно, ирония в том, что в состоянии диабета второго типа организм для компенсации резистентности к инсулину вырабатывает больше инсулина, а не меньше. То есть с токсичным инсулином организм борется, производя больше токсичного инсулина.
В этот же холистический подход у Берга вписывается еще и непонимание работы иммунитета как такового. Например, он рассказывает про то, что сами по себе болезни – это естественная реакция организма на патоген. Берг явно что-то путает. Наша реакция на болезнь, например, температура, может и правда быть адаптивной. Но как это отменяет тот факт, что инфекции вредят нам и сами по себе? А когда иммунитет поломан, например, при СПИДе, то даже обычный герпес становится смертельным.
Ещё довольно забавно, как Берг не любит “демонизацию” того, что ему нравится, но при этом сам демонизирует всё, что ему не нравится. Например, антибиотики! Это же неестественно, значит, вредоносно, вот он и сгущает краски об их побочках. Вообще адекватная человеческая логика в его словах по началу прослеживается. Действительно, из-за приема антибиотиков человек может вместе с плохими бактериями убить и хорошие, на их место придут патогенные – и тогда человеку снова придется принимать антибиотики, возможно, даже более мощные. А они могут и не помочь. И это реальная проблема. Или другой пример. Были у человека патогенные бактерии. Принимал он антибиотики, но убил их не до конца. И вот плохие бактерии остались, причем именно те, что были более устойчивы к антибиотику. Тоже реальная проблема.
А теперь выключаем человеческую логику и переходим к логике Доктора Берга. Из всего этого он делает вывод, что антибиотки превращают нормальные бактерии в патогенные. Не пытались бы мы их убить, бактерии работали бы с нами в команде, защищая организм. А теперь они на нас обозлились и присоединяются к атаке. Так что пейте лучше капустный сок – и будете здоровы. Но нет, антибиотики не делают из полезных бактерий патогенов. Более того, сама по себе устойчивость к антибиотикам энергозатратна, так что устойчивые к антибиотикам бактерии – в отсутствии антибиотиков – как правило, проигрывают конкуренцию и менее опасны.
Восьмой красный флаг. Продажа фигни
А теперь – один из самых популярных красных флагов для определения якобы врачей из интернета. Доктор пытается вам что-то продать. Не отправить в аптеку, а приобщить, скажем так… к его собственному бизнесу. Если человек снимает видео о потрясающей пользе БАДов, воды с электролитами, каких-то чудо-приборов, а потом случайным образом оказывается, что он же все эти прекрасные приблуды может вам продать… это повод поставить его научную объективность под сомнение.
Доктор Берг, конечно же, продает сомнительные БАДы. И можно найти кучу отзывов от людей, которые рассказывают, как эти чудо-пилюли им помогли. Все болезни отступили, а мир заиграл новыми красками. Чего уж там, под любой видеоролик с разносом Доктора Берга от настоящих врачей приходят десятки людей, которые рассказывают о пользе его советов. Подобные аргументы “а мне помогло”, основанные на личном опыте, не являются доказательствами эффективности чего-либо. Бывает, болезнь проходит сама, бывает, изначальный диагноз оказывается неправильным. Но если в этот момент вы будете совершать какие-то якобы лечащие действия, то будете списывать все эти изменения на их счет.
Но если кого-то убеждают личные истории, то справедливо посмотреть и на отрицательные отзывы. В которых люди не просто ругают БАДы Берга, а рассказывают, что доктор буквально испортил их жизнь. Кто-то пишет, что из-за его порошка с электролитами у него начались сильные боли. Ещё один комментатор жалуется, что из-за совета Берга удалять бородавки с помощью йода и чеснока у него теперь огромный шрам на лице. И после консультации за 300 долларов с настоящим врачом оказалась, что эта ядреная комбинация так проела несчастному кожу, что получившийся шрам даже нельзя полностью закрыть.
Девятый красный флаг. Примесь духовности
Нормальная медицина не имеет никакого отношения к религии, духовности и мистике. Врач может быть верующим, но не должен приплетать молитву, святую воду или чакры, когда речь идет о реальных болезнях. Человек, которым руководит в первую очередь не здравый смысл, не логика, а какие-то священные писания и мудрость предков, может быть очень опасен для пациентов.
И все же даже по этой шкале Доктор Берг всех переплюнул. В этом конкурсе он занимает первое место, потому, что выбрал самое дикое учение – саентологию. Да, оказывается, Доктор Берг – махровый саентолог! Все эти манипуляции, управление людьми, агрессивные продажи, обещание тайных знаний и возведение себя на пьедестал… опыт в саентологии может весьма пригодиться. Он просто взял ее приемы влияния и использовал для возведения своей псевдомедицинской империи.
Саентологи верят, что миллионы лет назад космический Лорд Ксену привёз миллиарды инопланетян на Землю, убил их и разбросал их души, которые теперь цепляются к людям и вызывают у них все проблемы. Интересно, что главное разоблачение на эту тему пришло откуда не ждали – от сына Доктора Берга. Которого отец тоже втянул в саентологию, заставил проходить специальное обучение, и парню пришлось буквально отвоевывать себе право самостоятельно распоряжаться своей жизнью вне этой секты. В своем видео он приоткрыл занавес саентологического кошмара, который происходит у Берга дома.
Частично он подтвердил то, что я уже написал. Доктор Берг на самом деле никакой не доктор, всех врачей он считает инструментами фармы и на самом деле клал громадный болт на медицину как таковую. Как и все саентологи, он не признает психиатрию. Ведь все ментальные проблемы, по учению секты, происходят от присосавшихся к людям душ инопланетян. И единственное, что беспокоит Берга – как сделать на людях деньги. А саентологи в этом действительно шарят. Их основатель Рон Хаббард так и говорил: хочешь заработать много денег – создай свою религию. И создал.
Ещё, по словам его сына, бизнес Берга насквозь пропитан религией. Настолько, что продвижение человека по карьерной лестнице в нем всегда обусловлено его успехами в познании саентологии. Большая часть его сотрудников – тоже саентологи. А те, кто таковыми не являются, обязаны проходить курсы, чтобы ими стать. Компания также существует, опираясь на этику саентологов, которая подразумевает их “этические расследования”. А именно – доносы, конфронтационные практики, приводящие к подавлению эмоций и критического мышления. Ну и другие попытки “исправить” бракованного члена коллектива, вплоть до изоляции от родных и друзей.
Самым показательным стал случай одной из сотрудниц, которая, будучи христианкой, отказывалась проходить саентологические курсы и ехать в специальный круиз. За это ее подвергли допросам с Е-метром. Это такая саентологическая приблуда, регистрирующая изменения электрического сопротивления человеческого тела. За непослушание девушку наказали снижением зарплаты и усиленным контролем. Заставляли посещать саентологическую церковь. Все закончилось ее жалобой в Комиссию по равным возможностям.
А ведь и правда есть некоторое сходство между альтернативной медициной и религией. Научных доказательств не требуется, а вот веры авторитетам – хоть отбавляй.
Вместо заключения
Подытожим. Если вы нашли у кого-то хотя бы один красный флаг — это уже повод насторожиться. А если таких флагов целая коллекция, как у Берга, то бежать надо без оглядки. Чаще всего одна глупость неизбежно тянет за собой другую. Сегодня хиропрактика, завтра вред вакцин, послезавтра – защита ауры от 5G с помощью масла орегано.
Я специально взял именно Доктора Берга, потому что он – настоящий бриллиант среди мракобесов. Витринный экспонат, сияющий всеми гранями лженауки. Только бриллиант этот фальшивый. А даже если бы он был настоящим, какая разница: бриллианты болезни не лечат, это делают врачи. С дипломами, а не с пузырьками гомеопатии и акупунктурными точками.
Подписывайтесь на соц. сети: